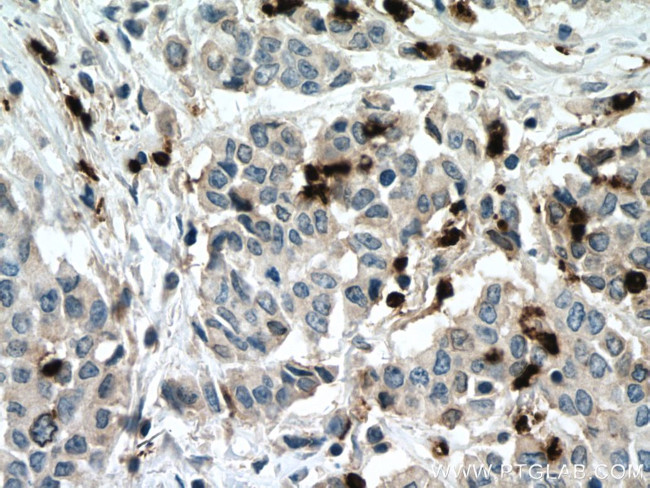
MPO Antibody in Immunohistochemistry (Paraffin) (IHC (P))

Search
Proteintech
MPO Polyclonal Antibody
{{$productOrderCtrl.translations['antibody.pdp.commerceCard.promotion.promotions']}}
{{$productOrderCtrl.translations['antibody.pdp.commerceCard.promotion.viewpromo']}}
{{$productOrderCtrl.translations['antibody.pdp.commerceCard.promotion.promocode']}}: {{promo.promoCode}} {{promo.promoTitle}} {{promo.promoDescription}}. {{$productOrderCtrl.translations['antibody.pdp.commerceCard.promotion.learnmore']}}
产品信息
22225-1-AP
种属反应
已发表种属
宿主/亚型
分类
类型
抗原
偶联物
形式
浓度
规格
纯化类型
保存液
内含物
保存条件
运输条件
产品详细信息
This antibody is specific to MPO.
Immunogen sequence: CGLPQPETV GQLGTVLRNL KLARKLMEQY GTPNNIDIWM GGVSEPLKRK GRV (606-657 aa encoded by BC130476)
靶标信息
Myeloperoxidase (MPO) is a heme protein that is synthesized during myeloid differentiation and is a major component of neutrophil azurophilic granules. It is produced as a single chain precursor and subsequently cleaved into a light and heavy chain. The mature MPO is a tetramer composed of 2 light chains and 2 heavy chains. This enzyme is responsible for producing hypohalous acids that are central to the microbicidal activity of neutrophils. Diseases that are associated with MPO include Myeloperoxidase Deficiency and Alzheimer's Disease, Familial, 1.
仅用于科研。不用于诊断过程。未经明确授权不得转售。
生物信息学
蛋白别名: MPO; Myeloperoxidase; unnamed protein product
基因别名: mKIAA4033; MPO
UniProt ID: (Human) P05164, (Mouse) P11247
Entrez Gene ID: (Human) 4353, (Mouse) 17523